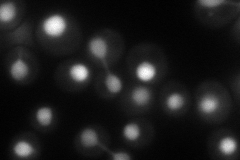
YNL102W
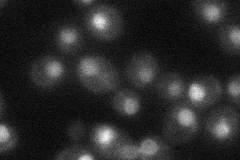
YNL102W
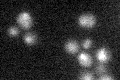
YNL102W

View description
Catalytic subunit of the DNA polymerase I alpha-primase complex, required for the initiation of DNA replication during mitotic DNA synthesis and premeiotic DNA synthesis
Localization:
Intensity:
Fold change:
Significance:
-
C’ GFP library in SD

nucleus30.66 -
N' NOP1pr-GFP in SD
nucleus69.1654 -
N' TEF2pr-mCherry in SD

nucleus31.9547 -
N' NATIVEpr-GFP in SD
nucleus36.8178 -
N' TEF2pr-VC and Cyto-VN in SD

nucleus36.5394 -
C’ GFP library in SD+DTT

technical problem0N/ANo -
C’ GFP library in SD+H2O2

nucleus31.051.01No -
C’ GFP library in Starvation Media
nucleus18.710.61Yes -
C’ GFP library on the background of Pup2-DaMP

nucleus -
C’ GFP library on the background of CCT mutant

nucleus33.56871.09448No
